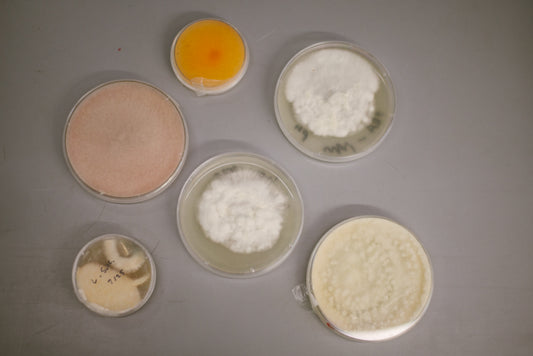

Oyster Mushroom Cultivation Tips for Bigger, Ta...
Oyster mushroom cultivation is on the rise in the U.S. and in locations around the world. It is not too surprising, especially since oyster mushrooms are delicious gourmet options that...
Oyster Mushroom Cultivation Tips for Bigger, Ta...
Oyster mushroom cultivation is on the rise in the U.S. and in locations around the world. It is not too surprising, especially since oyster mushrooms are delicious gourmet options that...

Our Lion’s Mane Mushroom Grow Kit May Be Good f...
Lion’s mane mushroom is an edible, gourmet mushroom that you can grow with the help of our special lion’s mane mushroom grow kit!
Our Lion’s Mane Mushroom Grow Kit May Be Good f...
Lion’s mane mushroom is an edible, gourmet mushroom that you can grow with the help of our special lion’s mane mushroom grow kit!

Chicken of the Woods Mushrooms: Delicious Info ...
As a professional mushroom farmer and an avid mushroom forager, my answer is a really young, tender, and fresh chicken of the woods mushrooms.
Chicken of the Woods Mushrooms: Delicious Info ...
As a professional mushroom farmer and an avid mushroom forager, my answer is a really young, tender, and fresh chicken of the woods mushrooms.

Growing Oyster Mushrooms at Home: TP is an Easy...
Today I’m talking about an easy way of growing oyster mushrooms at home, and I’m using toilet paper as the substrate. In the video below I use sawdust spawn but...
Growing Oyster Mushrooms at Home: TP is an Easy...
Today I’m talking about an easy way of growing oyster mushrooms at home, and I’m using toilet paper as the substrate. In the video below I use sawdust spawn but...

How Our Sterilized Mushroom Substrate Bags are ...
Today we take a look at the Fungi Ally lab, where we create a variety of sterilized mushroom substrate for commercial and hobby mushroom farmers. We can help you grow...
How Our Sterilized Mushroom Substrate Bags are ...
Today we take a look at the Fungi Ally lab, where we create a variety of sterilized mushroom substrate for commercial and hobby mushroom farmers. We can help you grow...

A Shiitake Mushroom Kit for Growing Your Own De...
Lovers of gourmet, edible mushrooms recognize the shiitake mushroom as a delectable treat. It is the most-consumed mushroom in Asia and the second most commercially-grown mushroom in the world. The...
A Shiitake Mushroom Kit for Growing Your Own De...
Lovers of gourmet, edible mushrooms recognize the shiitake mushroom as a delectable treat. It is the most-consumed mushroom in Asia and the second most commercially-grown mushroom in the world. The...

How a Mushroom Kit Will Expand Your Fungi Exper...
It is the perfect time for embarking upon your latest mushroom experience. One of our mushroom kit offerings is a great way to do just that. In the video below...
How a Mushroom Kit Will Expand Your Fungi Exper...
It is the perfect time for embarking upon your latest mushroom experience. One of our mushroom kit offerings is a great way to do just that. In the video below...

Shiitake Growing: Discover the 2 Most Popular C...
Many people turn to shiitake growing because they love the taste of this delicious mushroom. Today I’m sharing some information you need if you want to grow your own shiitake...
Shiitake Growing: Discover the 2 Most Popular C...
Many people turn to shiitake growing because they love the taste of this delicious mushroom. Today I’m sharing some information you need if you want to grow your own shiitake...

Mushroom Grow Bags Available: Oyster, Lion’s Ma...
We provide mushroom grow bags filled with an array of mushroom spawn, so you can start growing your own mushrooms at home
Mushroom Grow Bags Available: Oyster, Lion’s Ma...
We provide mushroom grow bags filled with an array of mushroom spawn, so you can start growing your own mushrooms at home

Growing Shiitake Mushrooms Outside for Deliciou...
It’s mid August and I wanted to share some methods for growing shiitake mushrooms outside. In the video below I showcase the Fungi Ally laying yard, where we have sawdust...
Growing Shiitake Mushrooms Outside for Deliciou...
It’s mid August and I wanted to share some methods for growing shiitake mushrooms outside. In the video below I showcase the Fungi Ally laying yard, where we have sawdust...
What is Mycelium: Nature’s World Wide Web Under...
What is mycelium and why is it so important? This is where the importance of understanding what mycelium is comes into effect.
What is Mycelium: Nature’s World Wide Web Under...
What is mycelium and why is it so important? This is where the importance of understanding what mycelium is comes into effect.

Seeking Cordyceps Mushroom in Shanghai, China: ...
On our first day in Shanghai we found cordyceps mushroom dried in a small traditional Chinese medicine shop. The shop had both wild cordyceps and some that were cultivated.
Seeking Cordyceps Mushroom in Shanghai, China: ...
On our first day in Shanghai we found cordyceps mushroom dried in a small traditional Chinese medicine shop. The shop had both wild cordyceps and some that were cultivated.